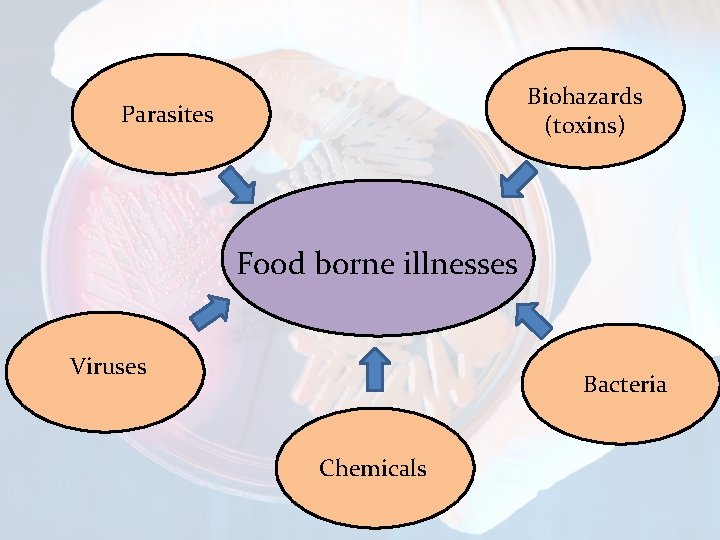
Biohazards (toxins) Parasites Food borne illnesses Viruses Bacteria Chemicals
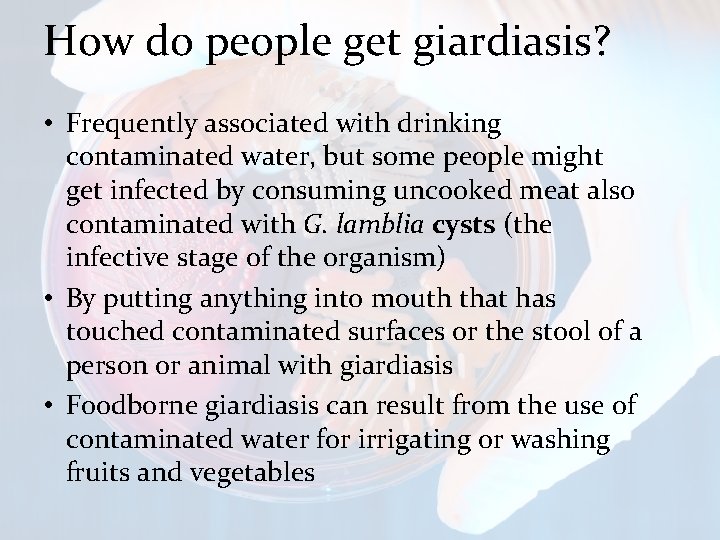
How do people get giardiasis? • Frequently associated with drinking contaminated water, but some
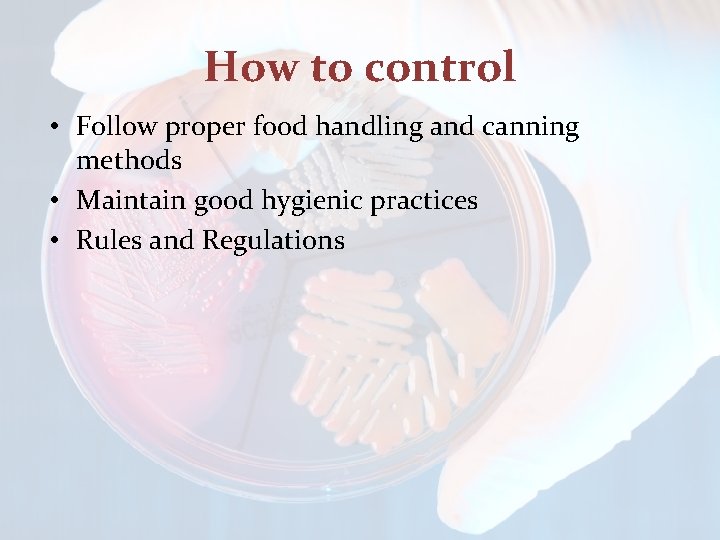
How to control • Follow proper food handling and canning methods • Maintain good
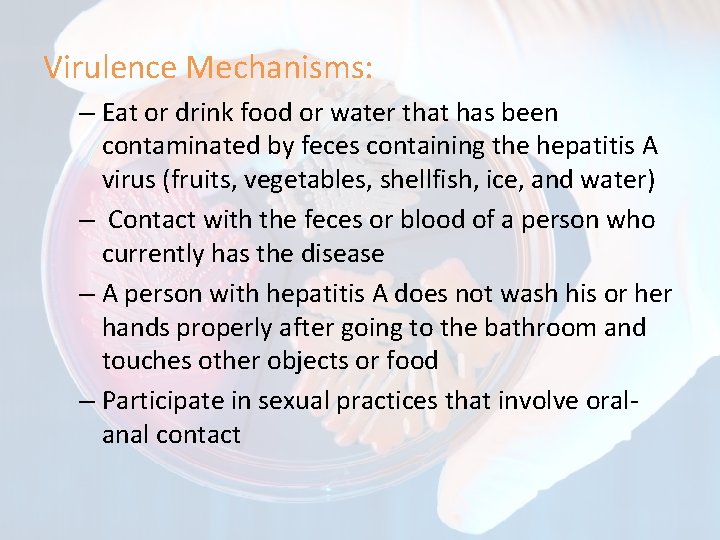
Virulence Mechanisms: – Eat or drink food or water that has been contaminated by

Food borne animal parasites viruses and food borne

Food borne animal parasites, viruses and food borne biohazards Dept. of Food Science & Technology Wayamba University of Sri Lanka 108072 108075 108078 108079
Biohazards (toxins) Parasites Food borne illnesses Viruses Bacteria Chemicals

Parasites

Parasites. . ? ? • Organisms that obtain their food from other living creatures • Smaller than their food source and this distinguishes them from predators which also eat other living things • Common food borne animal parasites - worms and protozoa • Worms include tapeworms (cestodes), flukes (trematodes) and roundworms (nematodes)


1. Protozoan Parasites • One-celled organisms but are larger and more complex than bacteria • Generally not susceptible to antibiotics that kill bacteria but there are effective drugs to treat some (not all) parasitic infections • Most common types; – Toxoplasma – Cryptosporidium – Cyclospora – Entamoeba – Giardia

Toxoplasma • Toxoplasma gondii • Obligate, intracellular, parasitic protozoan that causes toxoplasmosis • Infection in humans and other warm-blooded animals can occur – by consuming raw or undercooked meat containing T. gondii tissue cysts – by ingesting water, soil, vegetables, or anything contaminated with oocysts shed in the feces of an infected animal – from a blood transfusion or organ transplant – transplacental transmission from mother to fetus, particularly when T. gondii is contracted during pregnancy

Toxoplasma

Life cycle • Sexually reproduce only within the intestines of members of the cat family (felids)

Risk factors of toxoplasmosis and preventive methods • Diminished vision or blindness after birth of child, more severe effects include hydrocephalus, convulsions, and calcium deposits in the brain • Responsible for the deaths of AIDS patients and causes encephalitis in many immunosuppressed • Pregnant women and immunocompromised patients should avoid the following: – Raw or undercooked meat or eggs – Unpasteurized milk, particularly goat's milk – Contact with cat feces, including changing of cat litter trays

Cryptosporidium • Mainly Cryptosporidium parvum • Cause cryptosporidiosis, a parasitic disease of the mammalian intestine tract • Primary symptoms - acute, watery, and nonbloody diarrhoea • Other symptoms -anorexia, nausea/ vomiting and abdominal pain • The diagnosis of C. parvum consists of serological tests and microscopic evaluation of oocysts in stools using Kinyoun acid-fast staining

Life cycle

• The following groups have an elevated risk of being exposed to Cryptosporidium: – People who swim regularly in pools with insufficient sanitation – Parents of infected children – People who take care of other people with cryptosporidiosis – People who drink untreated water – People, including swimmers, who swallow water from contaminated sources – People who handle infected cattle – People who eat contaminated food; meat, fish, milk, fruits and vegetables

Cyclospora • Cyclospora cayetanensis • Cause cyclosporiasis • By consuming food or water contaminated with C. cayetanensis oocysts (the infective stage of the organism) • By putting anything into mouth that has touched the stool of a person or animal with cyclosporiasis

• Symptoms of cyclosporiasis; watery diarrhea (sometimes explosive), loss of appetite, bloating, stomach cramps, nausea, vomiting, muscle aches, low-grade fever, and fatigue • Symptoms are more severe in persons with weakened immune systems

Life cycle

Entamoeba • Entamoeba histolytica • An anaerobic, cause Amoebiasis • Transmission of the parasite occurs when a person ingests food/water that has been contaminated with infected feces • Cysts of the parasite are the viable form outside the host. They can survive weeks in water, soils and on foods under moist conditions. • An active Entamoeba infection will cause diarrhea

Life cycle

• On occasion, Entamoeba is capable of traveling to the liver

Giardia • Giardia lamblia • Single celled, flagellated, microscopic parasite that can live in the intestines of animals and people • Cause giardiasis • Giardiasis does not spread via the bloodstream, nor does it spread to other parts of the GI tract
How do people get giardiasis? • Frequently associated with drinking contaminated water, but some people might get infected by consuming uncooked meat also contaminated with G. lamblia cysts (the infective stage of the organism) • By putting anything into mouth that has touched contaminated surfaces or the stool of a person or animal with giardiasis • Foodborne giardiasis can result from the use of contaminated water for irrigating or washing fruits and vegetables

Life cycle

Symptoms of giardiasis • Most common symptoms- Diarrhea, abdominal cramps, gas, and nausea • Chronic infection might lead to dehydration and severe weight loss

2. Parasitic Worms • animals that typically have a long cylindrical tubelike body and no legs • Various types of worm occupy a small variety of parasitic niches, living inside the bodies of other animals. • There are three types of worms found which act as parasites. – Nematoda – Trmatoda – Cestoda

Anisakis and Pseudoterranova (Sealworm, Codworm) • Anisakiasis was first recognized as a human disease about forty years ago. • Found with fish • chub mackerel and flying squid in Japan and pickled anchovies, raw sardines, cold smoked salmon, raw or pickled herring are some vectors.

• Other fish, including whiting, mackerel, pollack, and flounder, may also contain these parasites with anisakid larvae. • varies by season and increases with fish size Water temperatures and seal populations may also affect the abundance of these parasites

The way of forming of Anisakis • Adult worms in these marine mammals produce eggs • That pass out with the feces, hatch, and the larvae are consumed by shrimp. • When fish or squid eat the shrimp, the larvae are released, bore through the stomach wall, • and may remain in the abdominal cavity or penetrate near by muscles. • The life cycle is completed when infected fish or squid are eaten by marine mammals

Life cycle of Anisakis

What’s happened when larvae are ingested by human ? ? ? • Humans are an accidental host and these larvae cannot mature in the human gut. Instead the worms burrow into the intestinal or stomach wall and may wander to the liver, lungs or other tissues, causing • gastric disturbances and allergic reactions. larvae found in herrings body cavity

Ascaris lumbricoides • Ascaris lumbricoides is a common intestinal roundworm parasite infecting an estimated one-quarter of the world’s population. • Lack of adequate hygiene could spread egg of this nematode to people who ingest contaminated foods and drink water.

Life cycle of ascaris • Humans are the only known host for this roundworm. • Eggs passed out with feces may be ingested by the same or another person • By drinks contaminated water, eats with dirty hands, or eats uncooked vegetables that have been fertilized with contaminated human wastes. • Upon ingestion, the eggs hatch in the intestine • The worms may migrate to the lungs or • liver before returning to the intestine and maturing.

Life cycle of Ascaris

What are the main causes of Ascaris ? ? • Infected babies become stunts growth and contributes to diarrheal infections and early childhood mortality. • Infected adults do not exhibit symptoms • these worms irritate the intestinal lining and interfere absorption of fats and protein. • Ascaris causes more severe infections in the liver or lungs.

Clonorchis/Opisthorchis (Liver flukes) • In eastern and southeastern Asia, several related parasitic worms of the genera Clonorchis and Opisthorchis lodge in the liver of infected humans and other animals causing blockage and hyperplasia of the bile passages.

The way of contamination occur • Cats and several other animals are vectors • Raw fish can spread this liver flukes • Additionally this will be a issue to some other countries like USA who are importing fresh water fishes of Asian countries.

Life cycle • Involve two intermediate hosts, snails and fish. • Humans and other fish-eating animals complete the life cycle by – eating raw, infected fish and digesting out the cysts. – Then the larvae migrate to the liver, mature, and produce eggs.


What happened after infection ? ? • Light infections cause mild symptoms like liver dysfunction • Heavier infections result in hepatitis and digestive disorders. • According to epidemiological reviews there is significant association between – chronic infection – liver cancer, – cholangiocarcinoma

Fasciolopsis buski (Fasciolopsiasis, Intestinal fluke) • F. buski is the largest trematode infecting humans, • Worms most commonly inhabit the intestines of farm pigs and school age children in Asian countries.

Life cycle of Fasciolopsis buski • This parasite requires a single intermediate host. • Eggs are deposited in feces, hatch in water, and the larvae penetrate snails and undergo development. • After 4– 6 weeks the parasites emerge from the • snails and encyst in water or on aquatic plants. • Consumption of contaminated water or of raw aquatic vegetables allows for completion of the life cycle


How is it infected. . ? ? ? • Consumption of – contaminated water – raw aquatic vegetables

Causes due to infection • Mild infection – Anemia, – headache, and gastric distress • Heavier infections – severe abdominal pain, malnutrition, edema – sometimes intestinal blockage.

cestoda

Taenia spp. • Most familiar worm found in intestine of human when they re infected. • there are number of species which used several animals as human, dog, even beares as there hosts.

• T. solium, in particular, may be present in as many as 20% of hogs • causes debilitating human disease that is difficult and expensive to treat


• Taenia life cycles involve two mammalian hosts. • Adults in the human intestine may live for more than twenty years, producing several thousand eggs daily • That pass out with the feces. • If these are consumed by an intermediate host, they develop into larvae (cysticerci) which migrate to the muscles. • Consumption of raw or inadequately cooked, infected beef or


How is it infected ? ? • • Via dirty hands or Fecally contaminated vegetables Contaminated water Or foods

Symptoms of infection • • Altered appetite Abdominal pain Diarrhea Constipation

Problems related with infection • Cysticercosis • The most serious consequences occur when the larvae reach the brain, causing neurocysticercosis • often triggers – headaches, seizures, and other neurological symptoms

Food borne Biohazards

Biotoxins • Biotoxin is a poisonous substance that is a specific product of the metabolic activities of a living organism (Plant, animal, bacteria, fungus) • Cause food intoxications • Toxicity depends on dose

Food Intoxication • Microbes grow in foods produce toxins • Toxins are ingested with the food and cause health problems • Most heat treatments are effective to kill microbes, but toxins remain

Toxin classification Organism Toxin Bacteria Botulinum toxin, Staphylococcus toxin Fungi Afalatoxin, Mycotoxin, Ochratoxin, Patulin Toxic algae Okadaic acid Natural toxins Histamine, Glycoalcoloids

Toxin characteristics • • Non replicative (Most are proteinaceous) Non transmittable (human to human) Nonvolatile Colorless Odorless Tasteless Most are stable at standard conditions

1. Botulism toxin • Agent: Chlostridium botulinum • Toxicity: 1 ng/kg – 500 g is enough to kill the human race • Disturb the acetylecholine mechanism at neuromuscular junctions • Symptoms – Nausea, vomiting, diarrhea, headache, lethargy, double vision, respiratory stress, death

Food sources • • Improperly canned foods (>p. H 4. 6) Smoked salmon, trout Fermented foods (Saeurkraut, pickled vegetables) Foods preserved in oil (Fish) Saeurkraut Canned foods

2. Staphylococcus toxin • Agent: Staphylococcus aureus • Toxicity: 1μg cause illness • Disturbs the regulation of intestinal fluid regulation system • Symptoms: – Sudden nausea, vomiting, excessive salivation, abdominal cramps, diarrhea, dehydration • Toxin is heat stable

Food sources • • Cooked ham, meat products, poultry Home made sausages Milk, cheese Cream filled pastries Cooked ham

3. Afalatoxin Agent: Aspergillus flarus Afalatoxin B 1, B 2, G 1, G 2 (B 1 is the most common) Toxicity: 0. 5 -10 mg/kg Liver cancer, chronic hepatitis, jaundice, cirrhosis (Low levels long time) • Cause acute toxicity, and potentially death (High exposure) • •

Food Sources • • • Peanuts and peanut butter Tree nuts such as pecans Corn Wheat Oil seeds such as cottonseed peanut butter

4. Ochratoxin • Agent: Aspergillus ochraceus • Toxicity: No documented acute toxicity in humans • Tolerable weekly intake 120 ng/kg (EFSA) • Has genotoxic and teratogenic effects • Relatively heat stable

Food Sources • • • Soy beans Coffee beans Grapes Peanuts Cereals Coffee beans Grapes

5. Patulin • Agent: Aspergillus clavatus. Penicillium expansum • Toxicity: No documented acute toxicity • Provisional maximum tolerable daily intake 0. 4μg/kg • Relatively heat stable and not destroyed by pasteurization

Food Sources • Apple and apple juice • Pears, grapes, bilberries may affect • Sweet cider Apple and apple juice


How to control • Good agricultural practices to avoid insect damages and mold infection • Good storage practices (Store below 100 C, control moisture, control RH) • Separation of contaminated foods before processing
How to control • Follow proper food handling and canning methods • Maintain good hygienic practices • Rules and Regulations

Food Born Viruses

Characteristics – Small microorganism – Parasites that replicate/ propagate themselves within suitable living host cells – Do not reproduce in food – Spread usually result of poor hygiene – Relatively stable and acid resistant outside host cells

Major 3 types Hepatitis A Rotavirus Food born viruses Norwalk Virus

1. Hepatitis A virus • Infection • Incubation: 10 -50 days • Deceases called as Hepatitis A Infection in humans occur – Eat or drink food or water that has been contaminated by feces containing the hepatitis A virus (fruits, vegetables, shellfish, ice, and water) – Contact with the feces or blood of a person who currently has the disease – A person with hepatitis A does not wash his or her hands properly after going to the bathroom and touches other objects or food – Participate in sexual practices that involve oral-anal contact

Hepatitis A cont. … • Virulence Mechanisms: – Ingest virus through food/water/fomite – Possibly infects intestinal cells – Moves to liver – Does not kill liver cells – Immune response - T-cell destruction of infected cells – Virus excreted in bile, then faces

Hepatitis A cont. … • Symptoms: 2 - 6 weeks after being exposed to the hepatitis A virus – systemic infection characterized by gastrointestinal manifestations and liver injury. • • • Sudden fever Vomiting Jaundice abdominal discomfort and bile in urine (Dark urine) Fatigue

2. Rotavirus • Infection • Incubation: 1 -3 days • Inflammation of the stomach and intestines Infection in humans occur – Ingestion of contaminated food or water – Direct contact with contaminated surfaces and then putting the hands in the mouth

Virulence Mechanisms: • Infects cells that line the small intestine cells • Produces enterotoxin • Induces gastroenteritis • Severe diarrhea and sometimes death through gastroenteritis Symptoms: – – Fever Stomach cramps vomiting, and diarrhea Dehydration

3. Norwalk Virus • Infection • Incubation: 12 to 48 hours • infection of the stomach and intestines Transitions: • – ready to eat foods, molluscs and uncooked – eating food or drinking liquids that are contaminated with norovirus, – touching surfaces or objects contaminated with norovirus then putting your fingers in your mouth, or – touched infected workers or any other foods contaminated with vomit or feces from an infected person

• Symptoms : – Nausea – Vomiting (more often children) – Diarrhea (more often adults) – Anorexia – Low grade fever, aches, chills, malaise • Recovery: 12 to 60 hours usually • Shedding up to 1 week! (feces, vomit)
Virulence Mechanisms: – Eat or drink food or water that has been contaminated by feces containing the hepatitis A virus (fruits, vegetables, shellfish, ice, and water) – Contact with the feces or blood of a person who currently has the disease – A person with hepatitis A does not wash his or her hands properly after going to the bathroom and touches other objects or food – Participate in sexual practices that involve oralanal contact

Referenes • http: //www. foodsafetywatch. org/category/fa ctsheets/biotoxins/

References: • www. slideshare. net
- Slides: 83